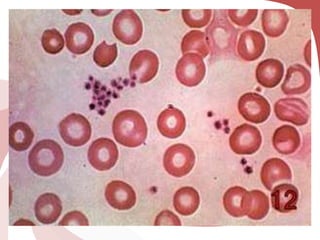

Este documento describe los diferentes elementos de la serie plaquetaria, incluyendo las plaquetas, los megacariocitos y sus precursores. Explica la estructura y función de las plaquetas, y su papel clave en la hemostasia, el proceso por el cual la sangre se coagula para detener el sangrado.

![Actividad de los factores de la coagulación sanguínea
[Proteínas disueltas en el plasma, que es la parte líquida de la sangre]
Simultáneamente, la acumulación de sangre fuera de los
vasos (hematoma) ejerce presión sobre el vaso, ayudando
a evitar más sangrado.
Al romperse la pared del vaso sanguíneo, una serie de
reacciones activan las plaquetas para que puedan
sellar la herida.](https://image.slidesharecdn.com/leucemiasyhemostasia-111226221112-phpapp01/85/Leucemias-y-hemostasia-48-320.jpg)















![El factor VIII se sintetiza en las células epiteliales de los sinusoides
hepáticos y en células mononucleares dispersas en bazo, riñón,
macrófagos alveolares y ganglios linfáticos.
El factor Von Willbrand se sintetiza en todas las células
endoteliales.
Los factores de coagulación son denominados con el nombre
Factor seguido de un número romano [rara vez se denomina al
Fibrinógeno como Factor I y al calcio como Factor IV].
A los factores plaquetarios se les denomina con un número
arábigo, y se conocen en la actualidad tan solo dos factores:
Factor 3 plaquetario (fosfolípido procoagulante de la membrana
plasmática)
Factor 4 plaquetario (granulos alfa de las plaquetas)](https://image.slidesharecdn.com/leucemiasyhemostasia-111226221112-phpapp01/85/Leucemias-y-hemostasia-64-320.jpg)


























































































































































































































































![• La alteración en la regulación inmunitaria se manifiesta en tres enfermedades:
– ANEMIA HEMOLITICA AUTOINMUNITARIA [AHAI]:
• Presente en el 11% de los casos
• La prueba directa de antiglobulina puede ser positiva hasta en 20% de los
pacientes.
– PURPURA TROMBOCITOPENICA INMUNITARIA [PTI]:
• Ocurre en 2 a 3% de los pacientes
• Presente en estadios tempranos y es posible que sea una manifestación inicial.
– APLASIA PURA DE SERIE ROJA [APSR]
• Puede verse en hasta en 6% de los pacientes con LLC.
• Se diagnostica poco pero si se considera y se realizan las pruebas adecuadas.
•
• El promedio de linfocitosis es de 87%.
• Las plaquetas se aprecian normales en 75%.
• Una o todas las inmunoglobulinas pueden estar disminuidas.
• 10% de los casos experimenta paraproteinemia.
• La MEDULA OSEA [MO] muestra abundancia celular aumentada en 60%de los
casos y normal en 24%.
• Los linfocitos oscilan entre 50 y 97% con promedio de 77.ç](https://image.slidesharecdn.com/leucemiasyhemostasia-111226221112-phpapp01/85/Leucemias-y-hemostasia-315-320.jpg)


